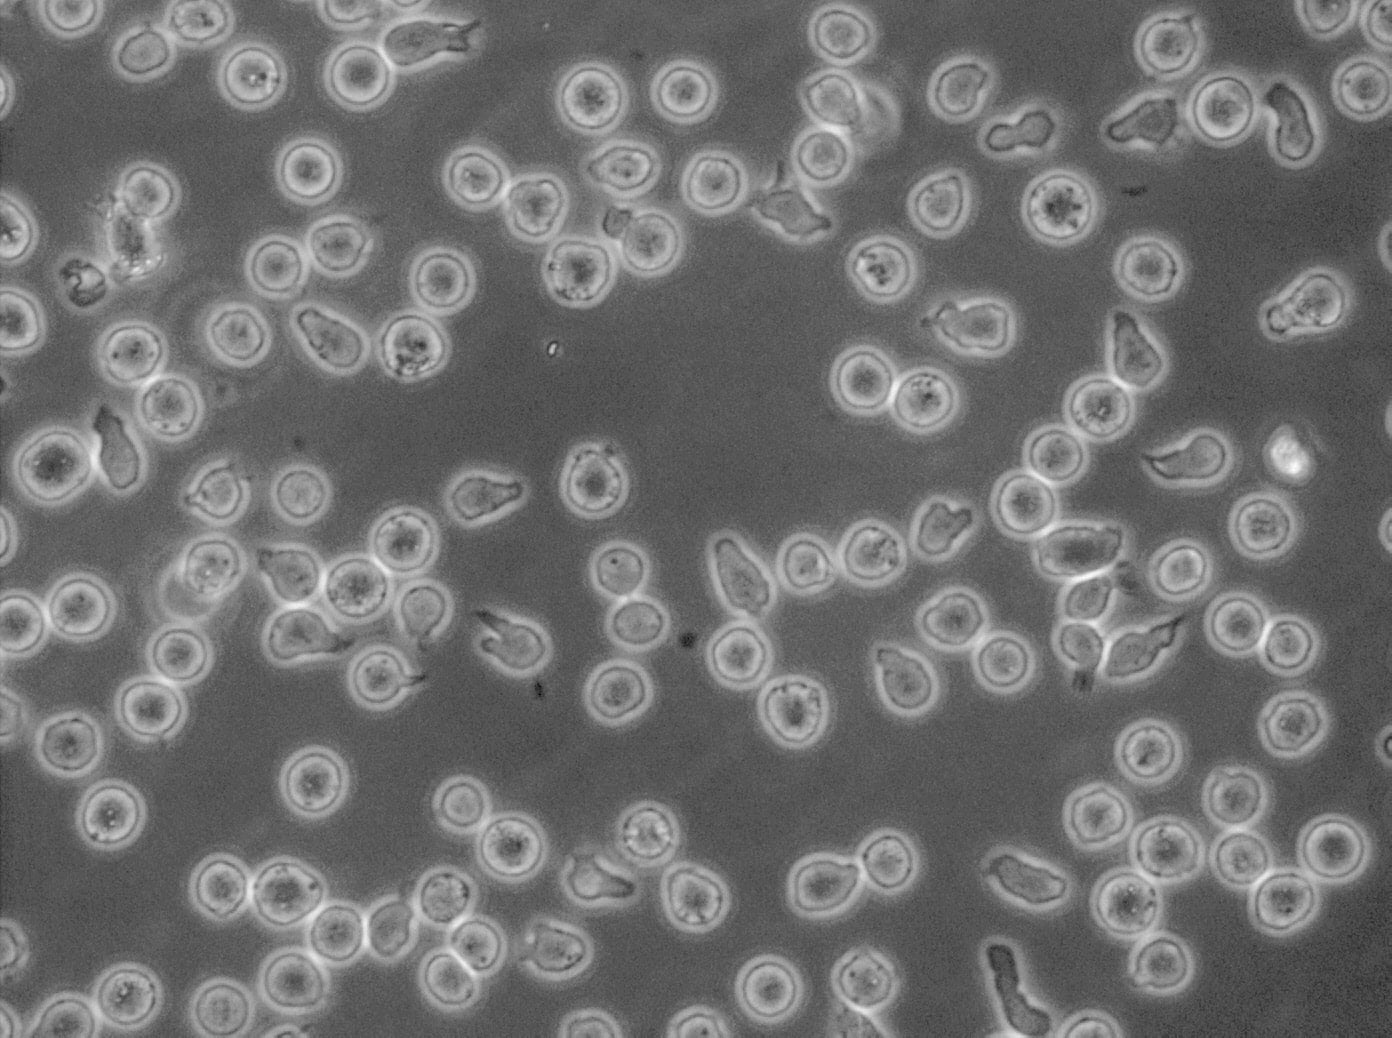
CD34+ progenitor cells

Welcome to PromoCell
Human Centered Science
We help scientists discover more every day by offering world-class cell culture products for research and industry applications that bridge the gap between discovery and clinical development.
About us
Find suitable products, scientific resources or answers to your questions within our technical library FAQ.